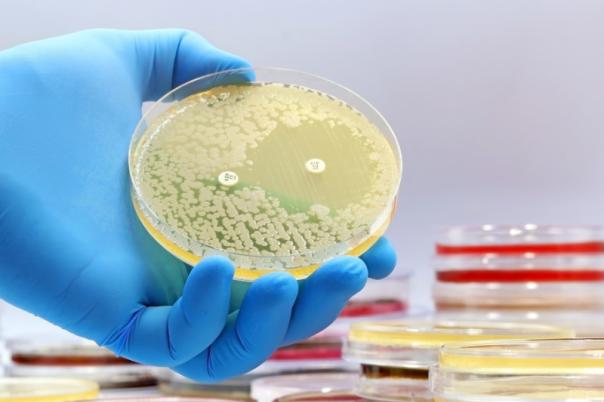
GSK and Fleming Initiative Scientists Team Up to Tackle AMR with AI

“Peptides make the perfect scaffold… They’re built from natural amino acids, are inherently biocompatible, and we can dial in chemistry and mechanics with precision.” — Prof. Aline Miller
From protein misfolding to precision scaffolds: Prof. Miller’s journey
Trained as a chemist and polymer scientist, Miller’s early work examined self-assembly—first in synthetic polymers, then in protein folding/misfolding. The variability of full-length proteins sparked a decisive shift: short, controllable peptide fragments that assemble into fibrillar networks with reproducible properties. A lectureship at UMIST (later merged into the University of Manchester) catalysed the lab’s platform, ultimately spinning out a company (Manchester BioGel) and informing clinical-minded research leadership.
Translation lessons learned: growth takes persistence; scaleup and hiring are hard; and academics can—and should—move innovations toward impact while returning insights to the lab.
What makes peptide hydrogels different?
Peptide hydrogels are tunable by design. Short sequences of around six to twelve amino acids let researchers control hydrophilicity and hydrophobicity, surface charge, π–π interactions and fibre–fibre association, producing fibrillar architectures that closely mimic extracellular matrix. Mechanically, these networks can be adjusted from roughly 50 Pa—soft enough to resemble brain tissue—to well over 10–20 kPa, firm enough to handle printing or injection while still allowing homogeneous cell mixing. Biochemical signalling can be encoded directly by adding recognition motifs such as RGD or collagen and laminin derived sequences into the peptide backbone at precise ratios, and animal-free growth factors can be blended into the matrix or medium to guide phenotype. Because the system is chemically defined, batch to batch consistency is markedly higher than with collagen or Matrigel, and the ethical burden of tumour derived ECM is eliminated. A practical note from the lab: most cell types favour neutral or positively charged scaffolds, while hepatocytes often prefer negatively charged matrices.
Organoids & disease models: delivering reproducibility and scale
In organoid systems, peptide hydrogels improve consistency by reducing lot-to-lot variability, enable genuine highthroughput by supporting single organoid deposition in multi-well formats, and simplify logistics as emerging formulations support room temperature transport that reduces reliance on cryopreservation. Together these features support more human relevant drug screening and pave the way for personalised workflows in which biopsy derived cells are introduced into ready-to-use gel protocols in clinical research settings.
Bioprinting: bioinks that support then step aside
Peptide gels satisfy core requirements for bioinks: shear thinning for intricate printing, cell compatibility, and on-demand degradation. As cells lay down their own ECM, peptide networks fade or are ingested, avoiding long term interference. They also lend themselves to composites (e.g., vascular channels within other polymers) for in vitro constructs.
Modular systems & the complexity question
With multi-material printing and layered architectures accelerating, the field faces a pragmatic decision: how complex is complex enough? Miller argues for model adequacy aligned to the question being asked—balancing biological fidelity against cost, robustness, and throughput.
The animal-free imperative
Moving fully animal-free reaches beyond the scaffold: media, supplements, and growth factors must also be defined and synthetic. Ethically compelling, this shift also sharpens predictiveness of human drug responses. Regulatory momentum—such as moves to phase down mandatory animal testing in some jurisdictions—converges with technological readiness and market availability.
“It’s not enough to grow an organoid instead of using a rabbit—every reagent around that organoid must be considered.” — Miller
Panel takeaways: challenges & solutions at scale
1) Variability, validation, and cost
Standardised supply chains and transparent validation are essential for regenerative applications that edge toward the clinic. Regulatory documentation remains heavy, and costs must be controlled if academic labs are to translate. The community can accelerate adoption by building open, shared datasets that validate animal-free pipelines and strengthen the case for investment.
2) Growth-factor reality check
Recombinant supplements produced in different expression systems—plant, bacterial or mammalian—often show different bioactivity, so one-to-one substitutions rarely work. Starting with chemically defined media removes serum variability; efficacy can then be tuned iteratively. Reproducibility ultimately depends on infrastructure and traceability, including cell source, passage number and every lot number in play.
3) Scaling complex models
Three-dimensional systems remain expensive across matrix, media and maturation time. Costs should fall as volumes rise, but for now careful cost–benefit analysis is essential. Practical controls help: purchase single lots of critical materials where possible and run small validation assays for each new growth-factor lot. And before defaulting to animal models, consider whether cell systems and computation can answer the question instead.
4) Automation and high throughput
Robotics expose genuine biological sensitivities rather than technician-to-technician variance. Under tracked variables—cell age, passage history and bank timing—strongly influence outcomes and must be logged from day one. As workflows automate, Matrigelcentric protocols often need alternatives such as peptide hydrogels, microcarriers or even matrixf ree approaches depending on lineage.
5) AI and computational modelling
AI can speed decisions such as engraftment suitability and scaffold design, yet remains data limited in stem cell contexts. Privacy preserving sharing standards will unlock far more value. Pairing public cell atlases with inhouse highthroughput data can help predict cell–cell interactions and guide model architectures.
What’s next: a practical roadmap
Go animal-free and chemically defined wherever you can today, replacing serum and animal matrices with peptide hydrogels and recombinant supplements while documenting every variable. Tune intentionally by screening mechanics, charge and ligand presentation per lineage. Design for throughput by enabling single organoid seeding, automation compatible handling and, where feasible, room temperature logistics. Instrument traceability—lot numbers, passage and culture age—from the first experiment and agree shared metadata with collaborators. Prioritise collaboration: publish negative data and contribute to open benchmarks for animal-free models. Explore AI responsibly by training on your own highthroughput datasets and layering in public atlases to prioritise constructs.